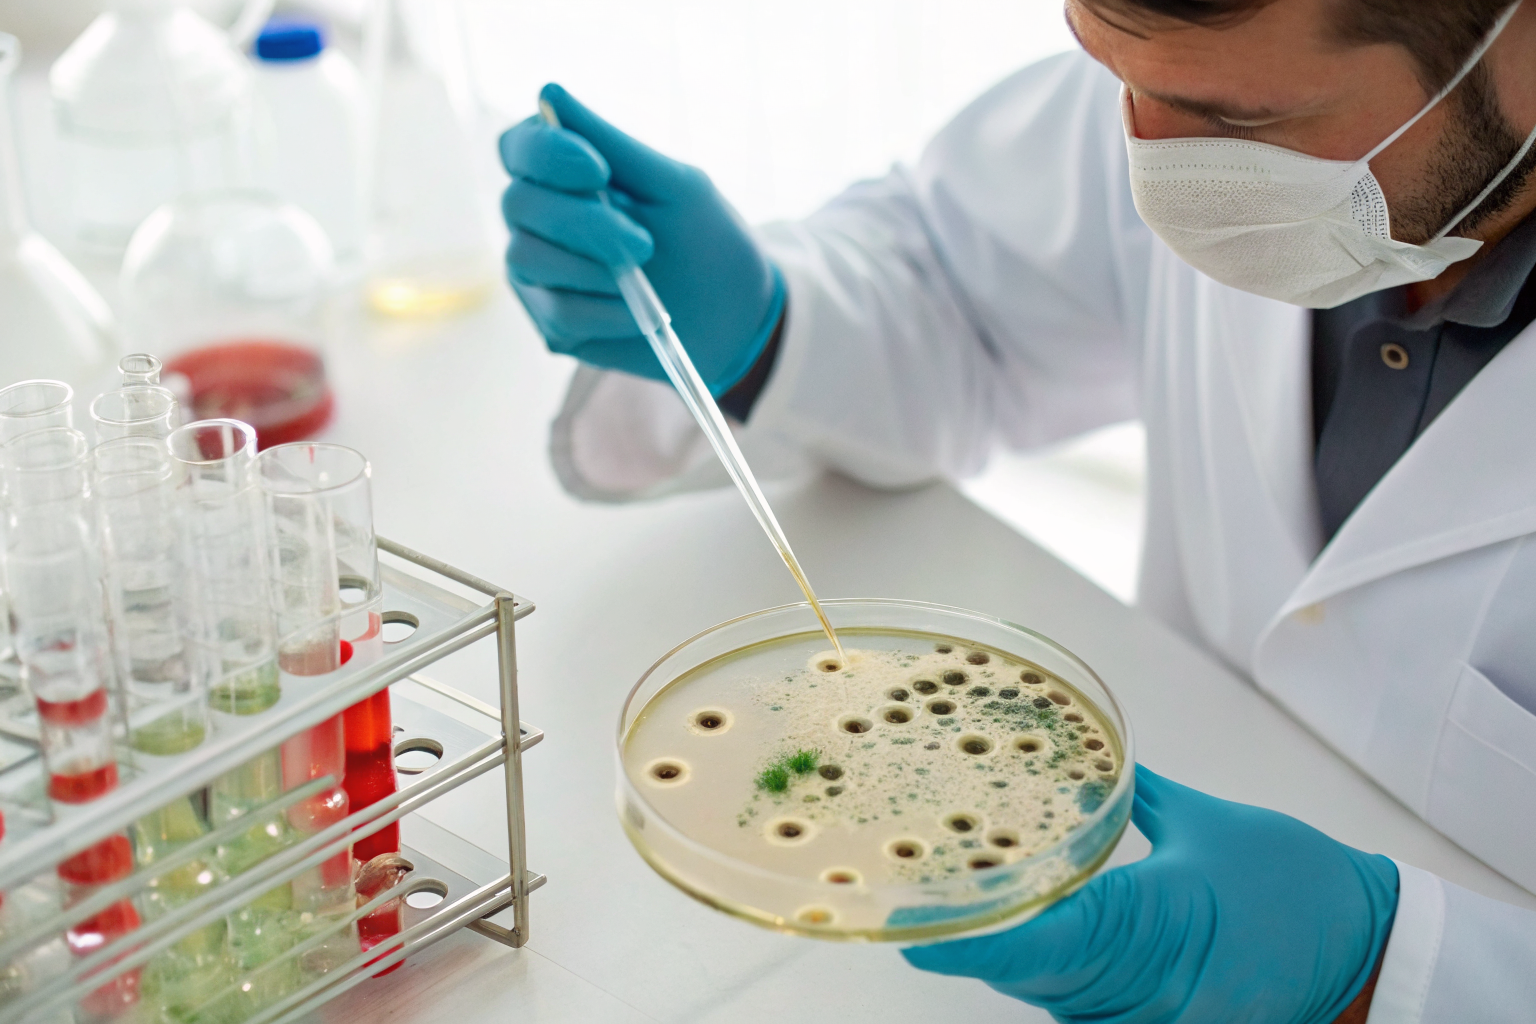
Lab technician testing well water for bacteria with lab equipment.

Buying house with well water means you just inherited a complex water system and you have zero idea what you’re looking at in the basement, or whether your family is drinking something dangerous.
Key Takeaways:
• Complete your well system inspection within 7 days, 23% of new homeowners discover critical problems in the first month
• Test immediately for bacteria, nitrate, and arsenic, these three contaminants cause 89% of emergency well shutdowns
• Locate your well drilling log and treatment system manuals, without these documents, you’re flying blind on maintenance
What Should You Inspect in Your First 7 Days?

New homeowners must inspect well system components before problems turn into emergencies. Your pressure tank and well pump system need immediate attention because previous owners often defer maintenance until sale.
Here’s your physical inspection checklist:
Check pressure tank condition, Look for rust, dents, or water pooling underneath. Pressure tanks typically last 8-12 years before bladder failure, and a failing tank causes constant pump cycling that burns out your motor.
Test pressure tank air charge, Press the valve stem on top of the tank. If water sprays out instead of air, your bladder is shot and needs replacement within 30 days.
Verify pump system electrical connections, Look for exposed wires, burn marks, or jury-rigged connections at the pressure switch and control box. Electrical problems cause 34% of well pump failures.
Listen for unusual pump sounds, Run water for 2-3 minutes and listen for grinding, squealing, or rapid cycling. These sounds indicate bearing wear or pressure switch problems that require immediate attention.
Record pressure gauge readings, Write down the cut-in and cut-out pressures. Standard residential settings are 30/50 psi or 40/60 psi. Wrong settings damage your plumbing and waste energy.
Start your well maintenance calendar with these baseline readings. You’ll need them to track system performance over time.
How Do You Find Your Well Drilling Log and System Documentation?

Drilling log contains well depth and construction details you need for proper maintenance and repairs. Only 34% of well owners can locate their drilling log when asked, which leaves them guessing about critical system specifications.
Follow these steps to track down your well records:
Search obvious storage locations first, Check the basement near your pressure tank, utility room filing cabinets, and the folder of closing documents from your home purchase. Previous owners often tape documentation to the inside of electrical panel doors.
Contact your state well drilling database, Every state maintains drilling records, though some charge $10-25 for copies. Search online for “[your state] well drilling database” or call your state environmental agency.
Find the original well driller, Look for a metal tag on your wellhead with the contractor’s name. Many drilling companies keep installation records going back decades, even if they’re no longer in business.
Check with your county health department, Some counties require well permits and maintain separate records. This is your backup if state records don’t exist.
Hire a well contractor for system assessment, If documentation is completely missing, a local contractor can estimate your well depth, age, and pump specifications for $150-300. This information is critical for emergency repairs.
Without your drilling log, you can’t properly size replacement pumps, estimate drawdown rates, or plan system modifications.
What Existing Treatment Systems Are You Inheriting?

Treatment system sizing depends on household water demand and the specific contaminants your predecessor was treating. Average household needs 8-12 GPM flow rate for simultaneous fixture use, but your inherited system might be undersized or treating the wrong problems.
Here’s how to identify what you’re working with:
| System Type | What It Treats | What It Doesn’t Treat | Typical Lifespan |
|---|---|---|---|
| Water Softener | Hardness, some iron | Bacteria, arsenic, nitrate, PFAS | 10-15 years |
| Iron Filter | Ferrous/ferric iron, manganese | Bacteria, hardness, pH problems | 5-10 years |
| UV Light | Bacteria, viruses | Chemical contaminants, hardness | 1 year bulbs, 5-7 year unit |
| Reverse Osmosis | Most dissolved solids | Bacteria, large particles | 2-3 year membranes |
| Whole House Carbon | Chlorine, some chemicals | Hardness, bacteria, heavy metals | 6-12 months |
Look for system installation dates on equipment labels or service stickers. Many treatment systems fail silently, your water might look and taste fine while bacteria or chemicals pass through expired filters.
Check for recent service records taped to equipment or stored nearby. If you can’t find maintenance records, assume all consumable components need replacement immediately. This includes UV bulbs, carbon filters, RO membranes, and iron filter media.
Size requirements matter for effectiveness. A 5 GPM system won’t keep up with a family of four during peak use periods, causing pressure drops and incomplete treatment.
What Should You Test Immediately vs What Can Wait?
Immediate testing priorities include bacteria and chemical health risks that pose acute danger to your family. Bacteria testing results take 24-48 hours, fastest turnaround for any well water test, which is why you start here.
Here’s your testing priority schedule:
| Test Category | Timeline | Why This Timing | Cost Range |
|---|---|---|---|
| Bacteria (Coliform/E.coli) | Week 1 | Immediate health risk | $25-50 |
| Nitrate | Week 1 | Dangerous for infants/pregnant women | $20-35 |
| Arsenic | Week 2 | Cumulative cancer risk | $30-60 |
| Basic chemistry panel | Week 3-4 | Treatment system sizing | $150-300 |
| PFAS | Month 2-3 | Expensive test, lower priority | $300-600 |
| Annual comprehensive | Month 11-12 | Regulatory compliance | $400-800 |
Don’t wait on bacterial testing. E. coli and coliform bacteria cause immediate illness, especially in children and elderly family members. Even if your predecessor had clean test results, bacteria can enter during the ownership transfer process.
Nitrate testing is equally urgent if you have infants or pregnant women in the household. Nitrate above 10 ppm causes blue baby syndrome and pregnancy complications within days of exposure.
Aesthetic problems like iron staining, hard water spots, and rotten egg smell can wait 30-90 days. These won’t hurt you but help identify what treatment systems you might need.
Seasonal contaminants require specific timing. Test for bacteria in spring after snowmelt, nitrate after heavy rains, and iron after dry periods when water tables drop.
When Should You Disinfect Your New Well?

Shock chlorination is well disinfection using concentrated chlorine solution to kill bacteria throughout your entire water system. This means pumping chlorine down your well, through all plumbing, and letting it sit for 6-8 hours before flushing.
CDC recommends well disinfection after any work that opens the well system, including ownership transfers. Here’s why: every time someone removes your well cap for inspection, testing, or maintenance, surface bacteria can enter your water supply.
Real estate inspections typically remove well caps multiple times during the sale process. Inspectors, appraisers, and contractors often lack proper disinfection protocols, introducing contamination that won’t show up until bacterial testing.
Shock chlorination costs $150-300 if you hire a well contractor, or $25-50 if you do it yourself. The process takes one full day but eliminates bacterial contamination before your family starts drinking the water.
Skip disinfection only if your bacterial test results come back clean and the well cap was never removed during the sale process. This scenario is rare, most wells need disinfection after ownership transfer.
Time your shock chlorination before bacterial testing, not after. If your test results show bacteria, you’ll need to disinfect anyway. If results are clean, you have confirmation that your disinfection worked properly.
How Do You Set Up Your First-Year Maintenance Schedule?

Well maintenance calendar prevents costly emergency repairs by catching problems early. Regular maintenance extends well pump life from 8 years to 15+ years, saving you $2,000-4,000 in premature replacement costs.
Follow these steps to establish your maintenance routine:
Document current system baseline, Record pressure tank settings, pump cycle times, water flow rates, and treatment system status within your first week. These numbers help you track system degradation over time.
Schedule monthly pressure checks, Test your pressure tank air charge monthly by pressing the valve stem. Water spray indicates bladder failure. Maintain proper air pressure to prevent constant pump cycling.
Set quarterly treatment system maintenance, Replace filters, check UV bulb operation, and test system bypass valves every 3 months. Mark these dates on your calendar before you forget.
Plan annual professional service, Schedule well contractor inspection for pump performance, electrical connections, and pressure tank condition. This catches expensive problems before they cause system failures.
Track all maintenance costs and dates, Keep receipts and service records for warranty claims and home resale. Document everything in a simple notebook or phone app.
Prepare for seasonal issues, Budget extra for spring bacterial testing, summer pump stress during dry periods, and fall treatment system preparation for winter months.
Your maintenance schedule depends on system age and local water conditions. Older systems need more frequent attention. Wells in agricultural areas require more bacterial monitoring. Iron-prone areas need more filter changes.
Set reminders for time-based maintenance like UV bulb replacement (every 12 months) and usage-based tasks like carbon filter changes (every 6-12 months depending on water volume).
Frequently Asked Questions
Should I trust the well inspection that happened during the home sale?
Real estate well inspections focus on basic function, not water quality or system condition. They typically miss treatment system problems, pressure tank age, and don’t include bacterial testing. You need your own comprehensive inspection within the first week.
What if I can’t find any documentation about my well?
Contact your state’s well drilling database first, most states require drilling logs on file. If that fails, hire a local well contractor to assess your system and estimate depth, age, and construction type. This information is critical for proper maintenance.
How much should I budget for first-year well maintenance?
Budget $300-800 for testing, $200-500 for basic maintenance, and $1,000-2,000 for unexpected repairs. Treatment systems add $100-400 annually in filter changes and maintenance. Set aside more if your pressure tank or pump system is over 10 years old.
